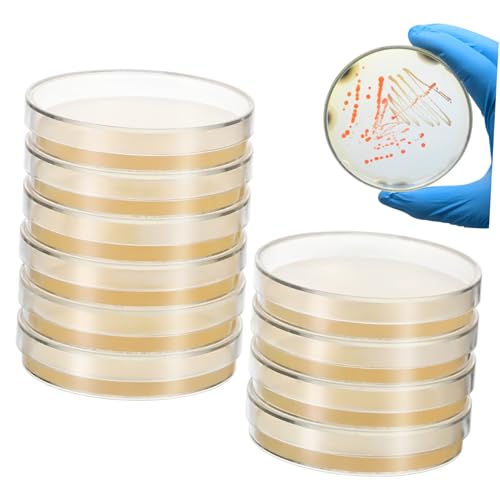
TEMPNAP 20 Stck Vorgefüllte Agarplatten mit Nährboden Sterile Petrischalen für Labor Wissenschaftsexperimente Mikrobielle Kultivierung Einfache Handhabung Vielseitig Einsetzbar in und von TEMPNAP

TEMPNAP 20 Stck Vorgefüllte Agarplatten mit Nährboden Sterile Petrischalen für Labor Wissenschaftsexperimente Mikrobielle Kultivierung Einfache Handhabung Vielseitig Einsetzbar in und
Produktbeschreibung
Vorbereitete nähragarplatten: diese vorgegossenen agarplatten mit kleiner größe, einfachem design, einfach und bequem zu verwenden, perei-gerichte mit agar Mikrobiologische petrischale: professionelles und praktisches design mit schlichtem erscheinungsbild, agarplatten sind leicht zu tragen und zu verwenden, labor-petrischalen Prepouref-nährstoff-agarplatten: diese professionellen und sicheren agarplatten sind vorgegossen und für den einsatz im labor geeignet. agarplatten für die Partyzubehör für die : die agarplatte besteht aus, was nützliches werkzeug für sie bei wissenschaftlichen experimenten ist, agarplatten für wissenschaftliche experimente Probenschalen: ideal für wissenschaftliche experimente, agarplatten sind sicher und nützlich, hervorragende leistung, vorgegossene agar-petrischalen
Produktvarianten, Größen und Optionen
Ähnliche Produkte finden
-von-Giessbach-3937999445.jpg)
-von-nobilia-4051856843.jpg)
-von-nobilia-4064752743.jpg)
-von-nobilia-4109878823.jpg)



